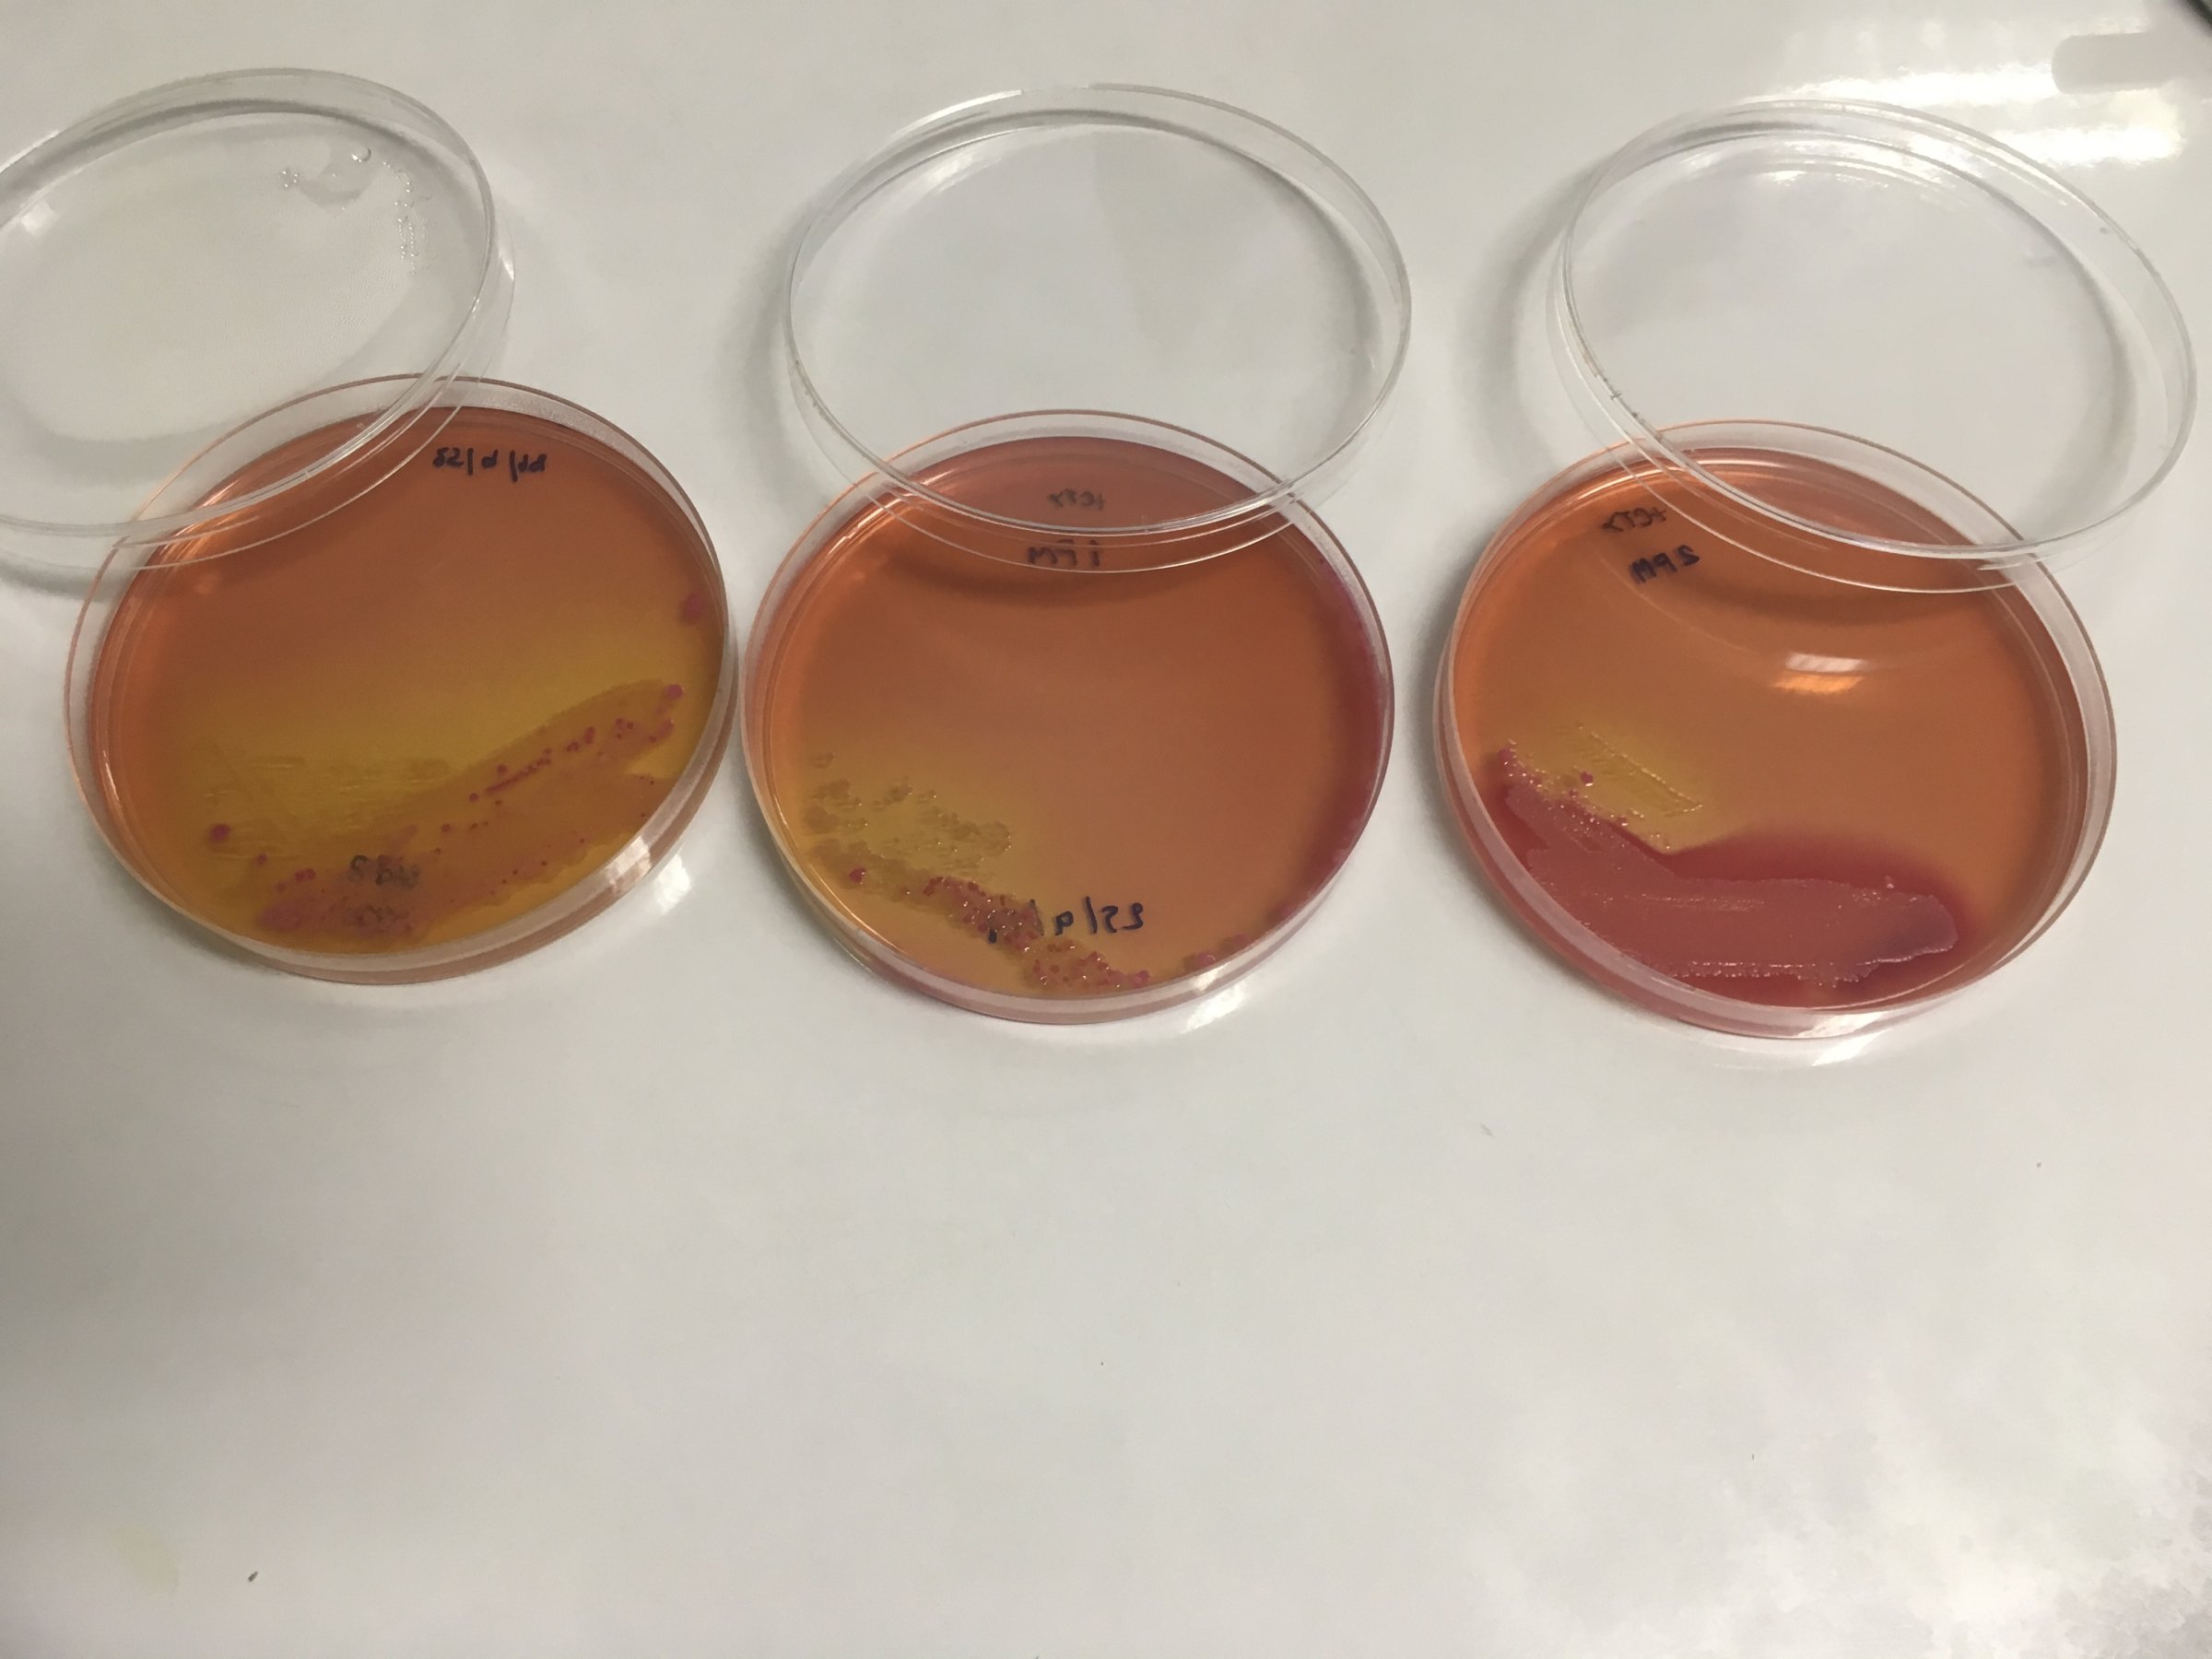

Veterinærinstituttet skal bidra til mindre antibiotikabruk i Thailand
Det internasjonale forskningsprosjektet REDUCEAMU hadde nylig oppstart, og feltarbeid og prøvetaking er allerede i gang. Prosjektet bruker svineproduksjon i Nord-Thailand som et case og skal teste ut tiltak som kan bidra til å redusere antibiotikabruk i produksjonen ved hjelp av datasimuleringer.

- Jeg var med på oppstarten av feltarbeidet og prøvetaking av svin og mennesker i Nord-Thailand og deltok også i oppstarten av lab-arbeidet ved Universitetet i Khon Kaen. Videre arbeid vil inkludere analyser av bakteriefunnene, det vil si resistente bakterier fra svin og mennesker, samt databearbeiding og modellering, forteller Marianne Sunde i seksjon for mattrygghet og nye helsetrusler ved Veterinærinstituttet. Hun er prosjektleder for den norske delen av prosjektet. Øvrige samarbeidspartnere er forskningsinstitusjoner fra Sverige, Sveits og Thailand, samt International Livestock Research Institute.
Samarbeidsavtale med Universitetet i Khon Kaen
Veterinærinstituttet har inngått en internasjonal samarbeidsavtale med Universitetet i Khon Kaen, Faculty of Veterinary Medicine i Thailand i forbindelse med samarbeidsprosjektet REDUCEAMU (Piloting on-site interventions for reducing antimicrobial use in livestock farming in emerging economies). Prosjektet er en del av et stort EU-prosjektsom har som mål å redusere antibiotikabruk i voksende økonomier. Et land med slik voksende økonomi er Thailand.
− Vi skal blant annet kartlegge og dokumentetere hva slags kunnskap og holdninger svinerøkterne har, hvordan svineproduksjonen foregår i praksis og hvordan produksjonen er organisert, styrt og ledet. Dagens eksisterende reguleringer rundt bruk av antibiotika synes å ha en begrenset og utilstrekkelig effekt på utvikling av antibiotikaresistens, derfor er det viktig å finne frem til andre og nye tiltak som kan ha bedre effekt, sier Sunde.
Veterinærinstituttet har ansatt to personer på prosjektet for å være med på feltarbeidet og prøvetaking i Thailand. Prosjektet vil gå over 3 år og skal ferdigstilles i 2020.